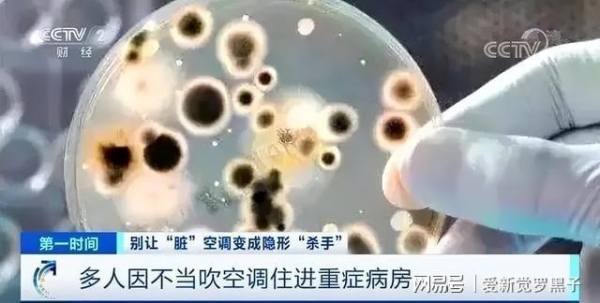

夏天到了,空调已经成为了家里面不可缺少的存在,外面的天气是越来越高,即便是室内温度有时候都达到了三十多度!
如果你是居住在低楼层还好,过了下午之后就能感受到凉爽,但你居住的是高楼,每天都要去面对闷热的天气,身体无时无刻的都在冒汗,只有打开空调才能感受到凉爽。
由于空调是用电大户,如何省电就成为了讨论的话题,比如,很多人都说空调搭配着风扇会更省电,这是真的吗?
其实空调和风扇一起开能够省电,这是说法也并不是没有道理的。
为什么是空调和风扇同时开能够省电?
空调的启停主要受室内温度的影响,室温达到设定的温度压缩机就会停机,想要压缩机停机更快,就得让温度更快的降下来。

虽然风扇不能降低空气中的温度,但是它能够让空调吹出来的冷气分散的更快更均匀,获得比空调所设置温度低1-2℃体感,从而让空调的温度感应器快速的检测到温度下降,达到快速停止压缩机工作的目的。
风扇空调同时开需要注意什么?这是很多人都忽略的,想要达到省电的目的,不仅仅是搭配风扇使用,还要用对方法才行。
①:空调的温度不要设置太低。
一边开空调一边开风扇,空调就不要设置太低的温度,
每天空调每调高1摄氏度可能降低7%~10%的用电负荷,
而电风扇的功率比空调要小很多,所以组合起来使用确实会更加省电。

②:最好搭配空气循环扇
其实风扇我们只要选择普通风扇就可以,但是如果想要快速降温的话,
也可以选择空调的好伴侣,空气循环扇。
怎么样让空调更省电?
①:不要频繁开关
有很多人为了空调省电,会频繁的开关空调,空调降到一定的温度就关掉,等到屋内的温度升高再开启空调,即使这样做反而会有损压缩机的寿命更容易耗电。

②:别给外机"穿衣"
很多人担心空调的外机日晒雨淋会降低其寿命,给它穿一件"雨衣",
其实这样做就是多此一举,空调外机在设计的时候就采用的是防水功能的材料,
如果给它遮挡住,会影响它的散热功能,反而会更加耗电,影响使用寿命。

③:定期清洁空调
除此之外想要空调更加省电,还要注意定期清洁空调,因为空调长时间不清洁,里面会有大量的污垢细菌,
这样就会导致压缩机拼命的工作,工作起来比较有"负担",所以更耗电。
清洁空调也不仅仅是为了省电,更为了我们自身健康着想,
因为空调本身内部就是一个非常潮湿的环境,
特别容易滋生细菌,尤其是人类的头号敌人--螨虫。
螨虫特别喜欢潮湿温热的环境,而空调内部最适合螨虫大量繁殖。
除此之外还有大肠杆菌,霉菌,空调不清洁吹出来的风必会就会携带细菌,污染空气,危害我们身体健康。
尤其是家里,有老人孩子的长时间,吹不洁净的空调会导致免疫能力下降,经常感冒发烧,患上空调病。
所以空调的清洁一定要重视起来,如果你不想找人上门来清洁,多花钱可以自己在家清洁使用这款【空调清洁剂】。
这款空调清洁剂是我一直在使用的,效果非常好,所以分享给大家,
它是泡沫状态的,不是液体不会产生滴漏,无需二次清洁。
因为自带一个长长的导管,所以更容易深入到缝隙的位置,我们只要将电源断开,然后将过滤网取下来
把清洁剂均匀的喷洒在空调内部和过滤网上面,静置5-10分钟,过滤网清洁干净之后重新装回空调。
开启空调运行20分钟,这样空调里面的细菌污垢就会顺着排水管排到室外了,
空调清洁干净了能够大幅度的提升制冷效果,
而且吹出来的风清新,自然不会携带细菌,更不会危害健康。
这款空调清洁剂的设计非常人性化,因为自带一个长长的导板,
所以就连车载空调空气净化器也能够清洁,
非常实用,性价比很高,一瓶能用很长时间,建议大家空调一个月清洁一次。










